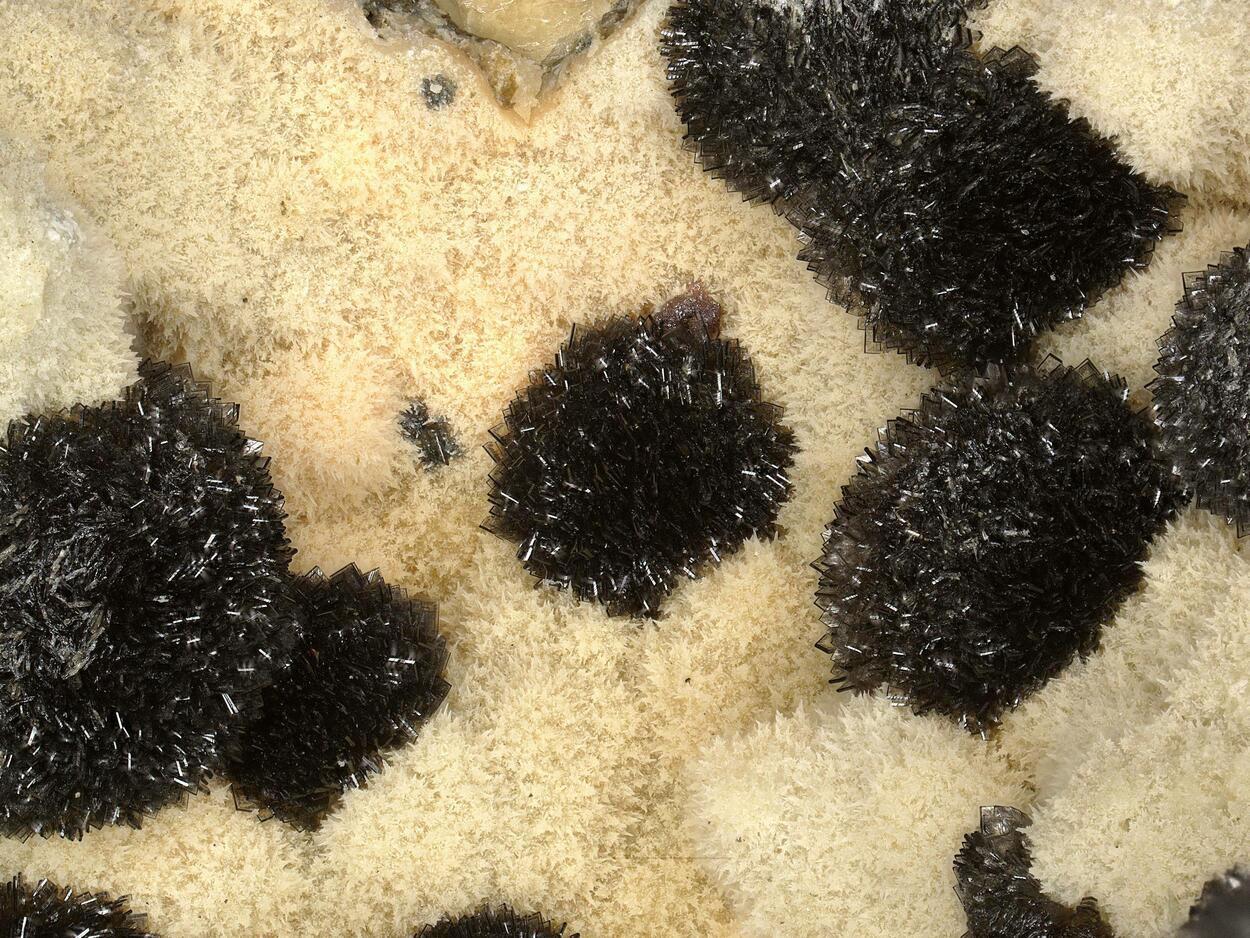
Childrenite

Childrenite
Auction Bidding
Check End Date/Time on Each Item
Closing Rules
Auction closes 10 minutes after End time or 10 minutes after last bid has been recieved.
Please Use your existing e-Rocks logon to access the Bidding Section.
Please ensure your User Profile details are up to date
or if new/forgotten your Password - Sign Up Now
When you are logged in a browser bar will appear at the top of each page, with your name to the right.
Please read the new e-Rocks T&Cs and Auction Rules - placing a bid confirms acceptance of these.
Once posted your bid will be held in the system even if outbid.
If a bid is lower than a reserve price, (Reserve Not Met) will display immediately and the bid will increment the auction price.
If a bid is higher than a reserve price, the bid will be set equal to the reserve price with (Reserve Met). The difference in bid above the reserve price is stored and private.
(You can view all your items by accessing My Items in your site browser bar.)
If you are outbid by default you will receive an automatic email - you can change these options in User Preferences.
Please do Feedback any problems/concerns